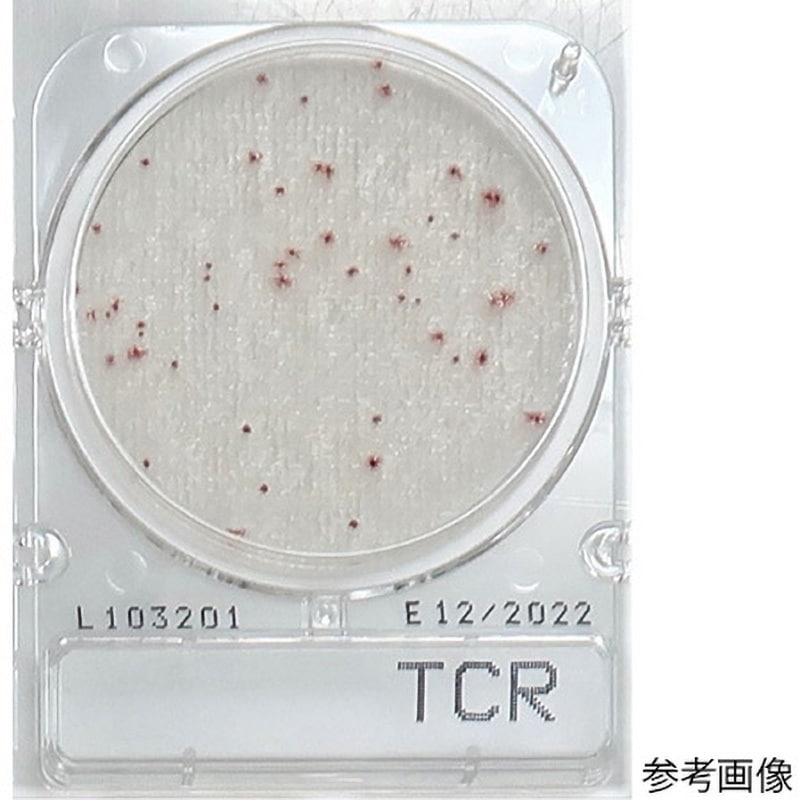
06540 コンパクトドライ 1箱(60袋×4枚) 島津ダイアグノスティクス 【通販モノタロウ】 25,546円

84652-B4011 (84652)ウインドシールド ワイパ スイッチASSY 1個 ダイハツ 【通販モノタロウ】
¥9,995 税込
在庫なし
新しいコレクション84652-B4011 (84652)ウインドシールド ワイパ スイッチASSY 1個 ダイハツ 【通販モノタロウ】
※一部登録商品においてメーカーの事情により、ご注文を頂いた後、廃番またはその他事情により入手が困難な場合は恐れ入りますがご注文をキャンセルさせて頂く事がございますので予めご了承ください。
※メーカー稼働日の事情または交通状況等により、表示している出荷目安に遅延が生じる場合がございます。
※一部梱包の都合上、部品番号ラベルが付随出来ないものも含まれます。
※お問合せの際には、車検証記載の『車名』『車台番号』とご希望の『部品名』が必要になりますので、お問い合わせの前にご確認頂きますようお願いいたします。
※寸法・形状など仕様についてのお問合せには対応いたしかねます。
※純正部品の交換の際は整備資格をお持ちの方による交換整備をお願いします。整備資格をお持ちでない方が交換整備した場合は一切の責任を負いかねます。
商品の説明
-
カテゴリー
-
レビュー
(4212)
-
送料・配送方法について
-
お支払い方法について
¥8 税込
-

62220-33190-B2 (62220)フロントピラー ガーニッシュ LH 1個 ダイハツ 【通販モノタロウ】
¥6,998
-

62210-33190-B2 (62210)フロントピラー ガーニッシュ RH 1個 ダイハツ 【通販モノタロウ】
¥6,998
-

81156-97202-000 (81156)リム. レフト (フオグ ランプ ヨウ) 1個 ダイハツ 【通販モノタロウ】
¥6,698
-

74110-B2100-B0 (74110)フロントアッシュリセプタクルASSY 1個 ダイハツ 【通販モノタロウ】
¥6,388
-

64262-97201-C0 (64262)ルーフ サイドレール ガーニッシュ RR RH 1個 ダイハツ 【通販モノタロウ】
¥6,698
-

55302-33270-C0 (55302)インストルメント パネルSUB-ASSY 1個 ダイハツ 【通販モノタロウ】
¥7,898
-

55302-33220-C0 (55302)インストルメント パネルSUB-ASSY 1個 ダイハツ 【通販モノタロウ】
¥6,998
-

62332-33110-C0 (62332)リヤドア オープニングトリム ウェザストリップ L 1個 ダイハツ 【通販モノタロウ】
¥7,698
-

62332-47040-C0 (62332)リヤドア オープニングトリム ウェザストリップ L 1個 ダイハツ 【通販モノタロウ】
¥6,398
-

62332-47040-B1 (62332)リヤドア オープニングトリム ウェザストリップ L 1個 ダイハツ 【通販モノタロウ】
¥6,998
-

62332-47040-B0 (62332)リヤドア オープニングトリム ウェザストリップ L 1個 ダイハツ 【通販モノタロウ】
¥6,398
-

62331-33110-C0 (62331)リヤドア オープニングトリム ウェザストリップ R 1個 ダイハツ 【通販モノタロウ】
¥7,698
-

62331-47040-C0 (62331)リヤドア オープニングトリム ウェザストリップ R 1個 ダイハツ 【通販モノタロウ】
¥6,398
-

62331-47040-B1 (62331)リヤドア オープニングトリム ウェザストリップ R 1個 ダイハツ 【通販モノタロウ】
¥6,998
-

62331-47040-B0 (62331)リヤドア オープニングトリム ウェザストリップ R 1個 ダイハツ 【通販モノタロウ】
¥6,398
-

55410-B2070-E0 (55410)インストルメントクラスタフィニッシュ パネルASSY 1個 ダイハツ 【通販モノタロウ】
¥7,998
-

55410-97201-C1 (55410)インストルメントクラスタフィニッシュ パネルASSY 1個 ダイハツ 【通販モノタロウ】
¥6,298
-

55410-33070-C0 (55410)インストルメントクラスタフィニッシュ パネルASSY 1個 ダイハツ 【通販モノタロウ】
¥6,998
-

62312-33090-C0 (62312)フロントドア オープニングトリム ウェザストリップ 1個 ダイハツ 【通販モノタロウ】
¥6,998
-

62312-47040-B1 (62312)フロントドア オープニングトリム ウェザストリップ 1個 ダイハツ 【通販モノタロウ】
¥6,998
-

62312-B1010-B0 (62312)フロントドア オープニングトリム ウェザストリップ 1個 ダイハツ 【通販モノタロウ】
¥5,898
-

62312-47040-B0 (62312)フロントドア オープニングトリム ウェザストリップ 1個 ダイハツ 【通販モノタロウ】
¥6,398
-

71706-B2010-E0 (71706)フロントシートバック ボードSUB-ASSY LH 1個 ダイハツ 【通販モノタロウ】
¥8,998
-

71706-B2040-E0 (71706)フロントシートバック ボードSUB-ASSY LH 1個 ダイハツ 【通販モノタロウ】
¥8,398
-

MB615564 (MB61)ガーニッシュ,フロント デッキ,RH 1個 ミツビシ 【通販モノタロウ】
¥5,398
-

TORY BURCH(トリーバーチ)エラ バイオスモールトート 145612
¥35,100
-
![[組立設置付]棚/コンセント付 すのこベッド [レイスター] スタンダードポケットコイルマットレス付 シングル ブラック [マットレス]黒 55,909円](https://gd.image-qoo10.jp/li/117/803/5309803117.jpg)
[組立設置付]棚/コンセント付 すのこベッド [レイスター] スタンダードポケットコイルマットレス付 シングル ブラック [マットレス]黒
¥55,909
-

【10点セット】LEDライト ネイルライト ネイルドライヤー ハンドヘルド レジン用 ネイルランプ Mini
¥17,497
-

H001-64-610B トレー アッシュ (H0) 1個 MAZDA(マツダ) 【通販モノタロウ】
¥8,235
-

【10%OFFクーポン】 シーリングライト LED 調光調色 おしゃれ 四角 三灯 北欧 省エネ スマホ リモコン操作 取付簡単 8畳 10畳 12畳 13畳 明るい 間接照明 可愛い インテリア 照
¥9,556
-

ダブルマジックIII 5EグレーL
¥6,970
-

Shiseido BOP アドバンス スーパー リバイタライジング クリーム
¥11,468
-

レディース メンズ 薄手 バスローブ 綿100 ミモレ丈 ホテル 春秋用 ユニセックス ワッフル バスローブ 膝下丈 男女兼用 ナイトガウン ユニセックス ナイトウェア
¥5,229
-

ニコン NIKKOR Z 28-135mm f/4 PZ NZ28-135
¥165,825
-

REAR32-300-M9NW サインロッドレスシリンダ/ダイレクトマウント形 REAR3 SMC 複動 シリンダ内径32mmストローク300mm
¥56,388
-

62480-32110-03 (62480)ルーフサイド ガーニッシュ INN LH 1個 トヨタ 【通販モノタロウ】
¥9,225
-

1A39-68-671 06 マットフロアー (1A39) 1個 MAZDA(マツダ) 【通販モノタロウ】
¥20,705
-
06540 コンパクトドライ 1箱(60袋×4枚) 島津ダイアグノスティクス 【通販モノタロウ】
¥25,546
-

コマツ PC90 アームシリンダー用シールキット
¥14,117
-

DRB-BK1212KK セミクローズドワークブース1212 井上金庫販売 寸法1200×1200×1900mm
¥194,900
-

CDQMB80-35-M9BWSDPCS 薄形シリンダ/ガイドロッド形 CDQMB80 SMC シリンダストローク35mm
¥29,585
-

SONY 交換用プロジェクターランプ LMP-H260
¥29,530
-

ナチュラルアニマルクリアボックス ギフト詰め合わせ お菓子箱 焼き菓子 服飾雑貨
¥9,900
-

レーヨン麻×チュールビスチェ「2024新作」
¥8,470
-

鰻重箱 日本製 10個セット うな重 重箱 和うなぎ 平曙(内朱) 鰻 (うなぎ) 重箱 漆器
¥24,500
-

ツバメ工業 テープ付クラフト封筒 角2 85g/㎡500枚
¥5,064
-

1856637500 (18566)BRACKET 1個 三菱ふそう 【通販モノタロウ】
¥26,256
-

manaco/オンブルー(2DVD付)
¥5,522